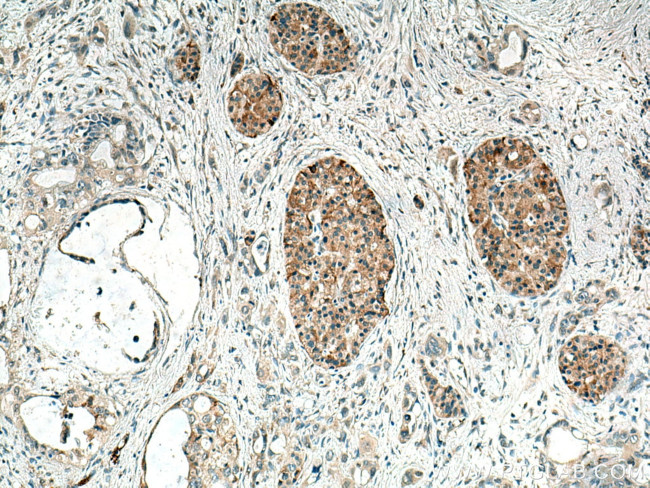
TMEM24 Antibody in Immunohistochemistry (Paraffin) (IHC (P))

Search
Proteintech
TMEM24 Polyclonal Antibody
{{$productOrderCtrl.translations['antibody.pdp.commerceCard.promotion.promotions']}}
{{$productOrderCtrl.translations['antibody.pdp.commerceCard.promotion.viewpromo']}}
{{$productOrderCtrl.translations['antibody.pdp.commerceCard.promotion.promocode']}}: {{promo.promoCode}} {{promo.promoTitle}} {{promo.promoDescription}}. {{$productOrderCtrl.translations['antibody.pdp.commerceCard.promotion.learnmore']}}
产品信息
25507-1-AP
种属反应
宿主/亚型
分类
类型
抗原
偶联物
形式
浓度
规格
纯化类型
保存液
内含物
保存条件
运输条件
产品详细信息
This antibody detects TMEM24 protein with MW 70-100 kDa.
Immunogen sequence: MDPGWGQRD VGWAALLILF AASLLTVFAW LLQYARGLWL ARARGDRGPG PALAGEPAGS LRELGVWRSL LRLRATRAGA AEEPGVRGLL ASLFAFKSFR ENWQRAWVRA LNEQACRNGS SIQIAFEEVP QLPPRASISH VTCVDQSEHT MVLRCQLSAE EVRFPVSVTQ QSPAAVSMET YHVTLTLPPT QLEVNLEEIP GEGLLISWAF TDRPDLSLTV LPKLQARERG EEQVELSTIE ELIKDAIVST QPAMMVNLRA CSAPGGLVPS EKPPMMPQAQ PAIPRPNRLF LRQLRASHLG NELEGTEELC CVAELDNPMQ QKWTKPARAG SEVEWTEDLA LDLGPQSREL T (1-350 aa encoded by BC022219)
靶标信息
Lipid-binding protein that transports phosphatidylinositol, the precursor of phosphatidylinositol 4,5-bisphosphate (PI(4,5)P2), from its site of synthesis in the endoplasmic reticulum to the cell membrane (PubMed:28209843). It thereby maintains the pool of cell membrane phosphoinositides, which are degraded during phospholipase C (PLC) signaling (PubMed:28209843). Plays a key role in the coordination of Ca(2+) and phosphoinositide signaling: localizes to sites of contact between the endoplasmic reticulum and the cell membrane, where it tethers the two bilayers (PubMed:28209843). In response to elevation of cytosolic Ca(2+), it is phosphorylated at its C-terminus and dissociates from the cell membrane, abolishing phosphatidylinositol transport to the cell membrane (PubMed:28209843). Positively regulates insulin secretion in response to glucose: phosphatidylinositol transfer to the cell membrane allows replenishment of PI(4,5)P2 pools and calcium channel opening, priming a new population of insulin granules (PubMed:28209843). [UniProt]
仅用于科研。不用于诊断过程。未经明确授权不得转售。
篇参考文献 (0)
生物信息学
蛋白别名: C2 domain-containing protein 2-like; C2CD2-like; DLNB23; KIAA0285; Phospholipid transfer protein C2CD2L; Transmembrane protein 24
基因别名: 1300006O23Rik; C2CD2L; DLNB23; KIAA0285; TMEM24
UniProt ID: (Human) O14523, (Mouse) Q80X80
Entrez Gene ID: (Human) 9854, (Mouse) 71764